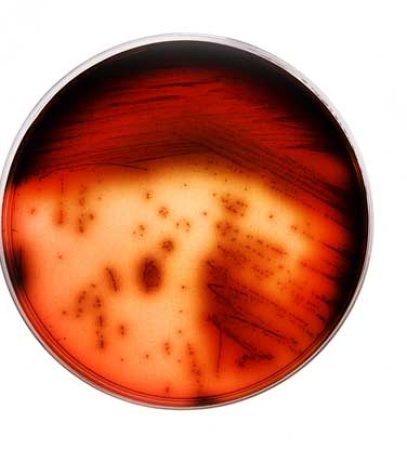
lysteria-producto

Descripción
Buffer Enriquecimiento Listeria Selectivo FDA/ BAM 1995 para realizar enriquecimiento selectivo de Listeria spp en 25g de muestra. Placas de Petri conteniendo medio Agar Cromogénico Listeria ISO 11290 que permite la diferenciación de Listeria monocytogenes respecto otras Listerias spp. Placas de Petri conteniendo PALCAM para la detección de Listeria spp.